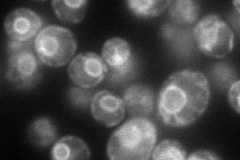
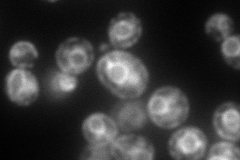
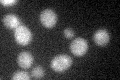

View description
Protein localized to COPII-coated vesicles, forms a complex with Erv41p; involved in the membrane fusion stage of transport
Localization:
Intensity:
Fold change:
Significance:
-
C’ GFP library in SD

below threshold15.66 -
N' NOP1pr-GFP in SD
ER116.067 -
N' TEF2pr-mCherry in SD
ER178.515 -
N' NATIVEpr-GFP in SD

ER65.7274 -
N' TEF2pr-VC and Cyto-VN in SD

#N/A0 -
C’ GFP library in SD+DTT
cytosol13.990.89No -
C’ GFP library in SD+H2O2

cytosol15.330.97No -
C’ GFP library in Starvation Media

cytosol15.741No -
C’ GFP library on the background of Pup2-DaMP

below threshold -
C’ GFP library on the background of CCT mutant

below threshold15.74451.00479No
